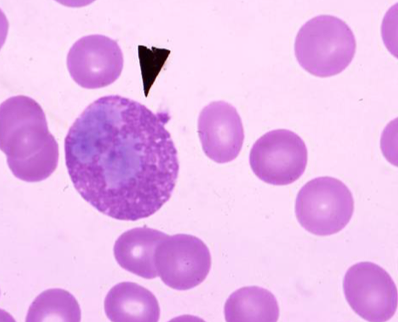
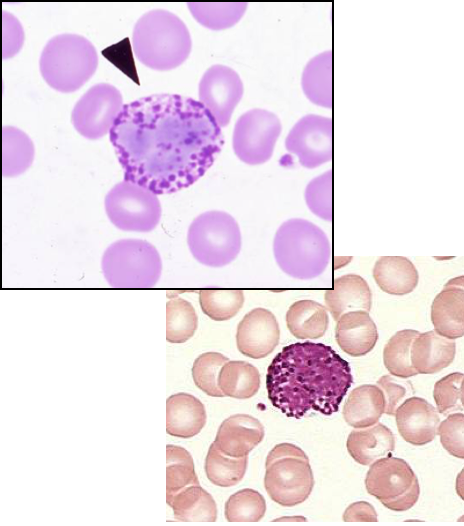
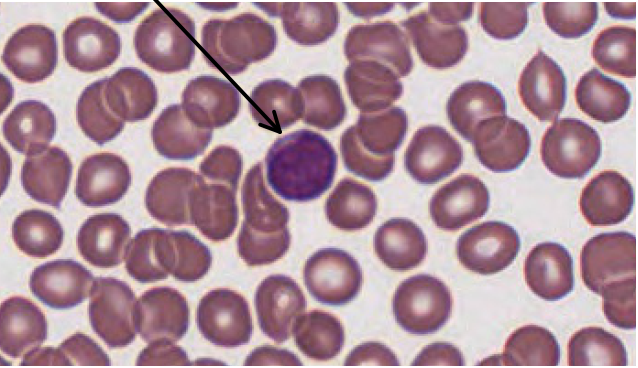
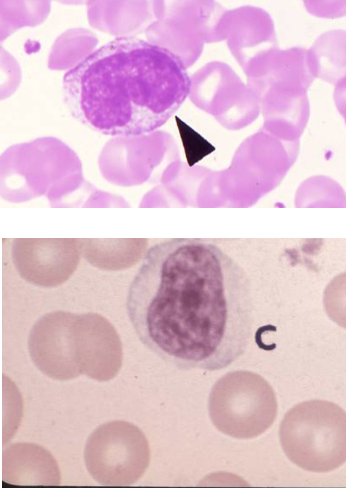
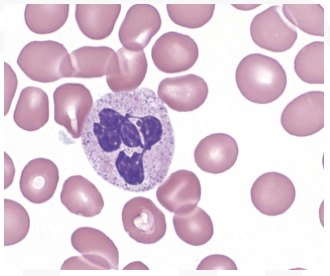

Erythrocyte diameter and lifespan:
Diameter: 7 micrometers
Lifespan: 120 days
Neutrophil diameter and frequency:
Diameter: 12 micrometer
Frequency: 60-70% of WBCs
What cell is shown in this slide?

This is a neutrophil (note the characteristic multi-lobed nucleus)
What cell type is shown in this slide?
Eosinophil
What is the diameter and frequency of an eosinophil?
Diameter: 12 micrometer
Frequency: 2-4% of WBCs
What is the diameter and frequency of a basophil?
Diameter: 10 micrometer,
Frequency: 0.5 - 1% of WBCs
What cell is shown in this slide?
Basophil
What is the diameter and frequency of lymphocytes?
Diameter: 10 micrometers,
Frequency: 20-25% of WBCs
What is shown in this slide?
Lymphocyte
What is the diameter and frequency of monocytes?
Diameter: 15 micrometers,
Frequency: 3-8% of WBCs
What cell is shown in this image?
Monocytes
What is the diamater of a platelet?
3 micrometers
Describe the stages of erythropoieses:
Erythropoieses is the process of RBC maturation/production. Cells get smaller and pinker on slides as they mature. There are 6 main steps:
- Proerythroblast,
- Basophilic erythroblast,
- Polychromatic erythroblast,
- Orthochromatophilic erythroblast,
- Reticulocyte,
- Erythrocyte

Describe basophilic erythroblasts:
Moderately sized, strongly basophilic cells. These are the first cells to look for on a slide.

Describe polychromatophilic erythroblasts:
These are the third stage of erythropoiesis. These are cells with increasing acidopilia and pyknotic nuclei (condensing chromatin during apoptosis).

Describe orthochromatophilic erythroblasts:
These are the fourth step of erythropoiesis. These are smaller nucleated cells with cytoplasm that is close to the color of mature erythrocytes (pinker). Very short-lived.

Describe reticulocytes:
These are the final stage of development before mature RBC. While reticulocytes are found in both bone marrow and peripheral blood, they are difficult to identify without stains such as cresyl blue.

Describe the process of granulopoiesis:
Granulopoiesis is the process of granulocyte (neutrophil, eosinophil, and basophil) maturation. Stages:
- myeloblast,
- promyelocyte,
- myelocyte,
- metamyelocyte,
- stab cell,
- mature cell (e.g. neutrophil)

Describe promyelocytes:
Promyelocytes are large cells with conspicuous azurophilic granules.

Describe myelocyte cells:
Myelocytes show specific granules, a nucleus that is slightly flattened or indented, and a hint of a Golgi region.

Describe metamyelocytes:
Metamyelocytes show a sharply indented nucleus in a V or U shape and a lightly stained Golgi region; the nucleus is frequently obscured by the distinctive granules in developing eosinophils and basophils (whereas developing neutrophils do not have these)

Describe band, or stab, cells:
Stab cells have a horseshoe shaped nucleus

What is the function of this cell?
This is a neutrophil - it phagocytoses, kills, and digests bacteria
What are azurophilic and specific granules?
Azurophilic granules are lysosomes (very small) containing various hydrolytic enzymes. “Specific granules” (which make a granulocyte a granulocyte) are very small and hard to see in the neutrophil, but they are present; these specific granules contain various enzymes and other molecules in the neutrophil.


















































